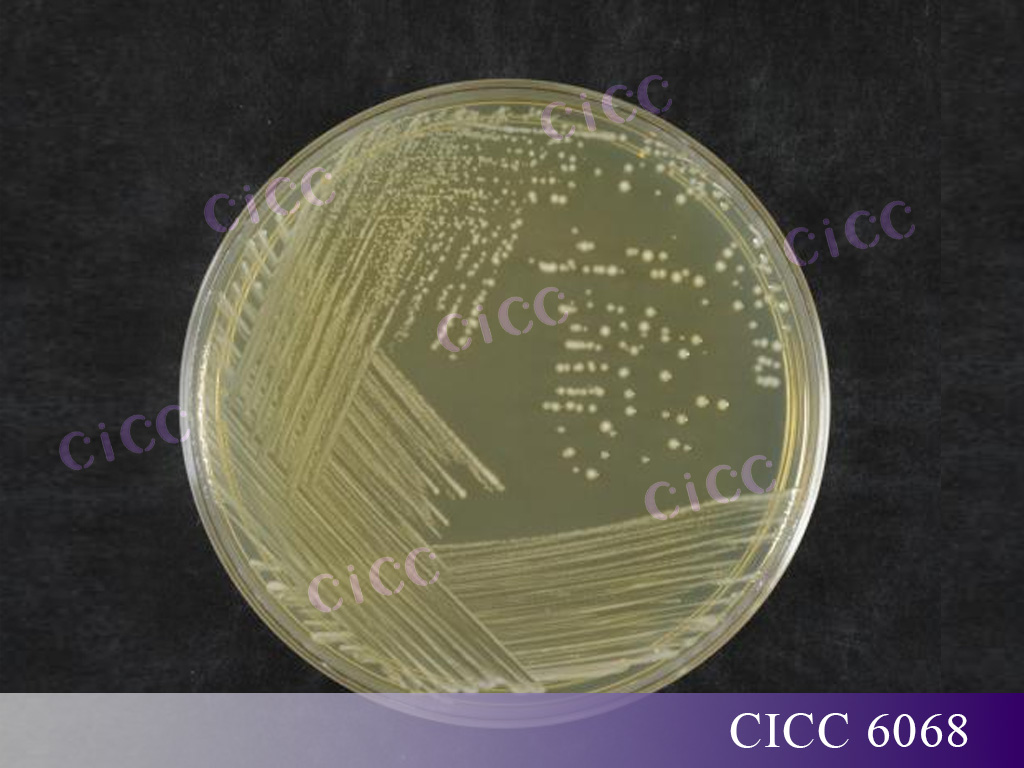

長雙歧桿菌 Bifidobacterium longum
放線菌門 Actinomycetota
放線菌綱 Actinomycetes
雙歧桿菌目 Bifidobacteriales
雙歧桿菌科 Bifidobacteriaceae
雙歧桿菌屬 Bifidobacterium
長雙歧桿菌廣泛存在于人和動物的腸道中,是歐洲食品安全局(EFSA)資格認定(Qualified Presumption of Safety, QPS)名單收錄菌種、美國食品藥品監督管理局(FDA)公認安全物質(Generally recognized as safe, GRAS)名單收錄菌種。是我國《可用于食品菌種名單》和《可用于嬰幼兒食品的菌種名單》收錄菌種[1]。
本文將詳細介紹長雙歧桿菌的發展歷史、特征特性、研究進展以及國內外保藏情況,以期加深大家對長雙歧桿菌的認識。
Part 1發展歷史
長雙歧桿菌最早由法國巴斯德研究所的兒科醫生Henry Tissier于1899年從母乳喂養的嬰兒糞便中分離得到,并將這種分離到的革蘭氏陽性、變彎的或分叉的桿菌命名為普通分叉桿菌 (Bacillus bifiduscommunis)或分叉桿菌(Bacillus bfidus)[2]。
1924年:OrlaJensen 提議將雙歧桿菌分類作為一個獨立的屬,但早期的雙歧桿菌分類主要基于傳統的菌落菌體形態、生理生化特性等,而這些方法經常無法將其與其他產乳酸細菌區分開,因此《伯杰氏細菌學鑒定手冊》第1-4 版將其取名為 Bacterodes bifidus,歸到擬桿菌屬(Bacteroides)中,又由于它與乳酸桿菌的相似性,《伯杰氏細菌學鑒定手冊》第5-7 版將其命名Lactobacillus bifidus ,歸類于乳桿菌屬 (Lactobacillus)。
1974年:《伯杰氏細菌學鑒定手冊》第8版首次將其劃分為獨立的雙歧桿菌屬(Bifidobacterium),隸屬于放線菌門(Actinobacteria)、雙歧桿菌科(Bifidobacteriaceae),當時屬內有 11 個種。
20世紀90年代末:原核微生物分類從傳統的基于表型的分類過渡到基于16S rRNA的系統進化分析的多相分類學框架[3]。根據特異性基因PCR擴增(rec A等)、脈沖電場凝膠電泳(PFGE)、熒光原位雜交(FISH)等多重技術驗證,2012年出版的《伯杰氏系統細菌學手冊》確認雙歧桿菌屬有32個種和9個亞種[4]。包括長雙歧桿菌長亞種(Bifidobacterium longum subsp. longum)、長雙歧桿菌嬰兒亞種(Bifidobacterium longum subsp. infantis)、長雙歧桿菌豬亞種(Bifidobacterium longum subsp. suis)。
2015年:研究人員基于多位點序列分析(MLSA)、多位點序列分型(MLST)和擴增片段長度多態性分析(AFLP),揭示了一個新的長雙歧桿菌亞種——Bifidobacterium. longum subsp. suillum[5]。
2023年:根據全基因組多位點序列分型(wgMLST)分析,并結合基因型、生態學和表型分析的一致結果,又發現了一個新的亞種,命名為Bifidobacterium longum subsp. iuvenis[7]。
截止到2023年,長雙歧桿菌共有五個亞種:
長雙歧桿菌長亞種(B. longum subsp. longum)
長雙歧桿菌嬰兒亞種(B. longum subsp. infantis)
長雙歧桿菌豬亞種 (B. longum subsp. suis)
B. longum subsp. suillum
B. longum subsp. iuvenis
Part 2長雙歧桿菌的研究進展
長雙歧桿菌作為一類獨特的益生菌,其嚴格厭氧、結腸定植等特性均顯著差異于其他菌株[8-9],這也賦予其特有的益生功能,在維持機體腸道微生態平衡、抑制致病菌入侵和調節機體免疫能力、降低膽固醇含量等健康方面發揮重要作用。
長雙歧桿菌作為腸道中的優勢菌群能有效抑制腸道致病菌,通過產生有機酸如乳酸、乙酸等和分泌抗菌化合物如細菌素等代謝產物,來有效地降低環境中的pH,抑制不耐酸病原體的生長和繁殖,甚至隨著胞內有機酸的積累導致致病菌死亡[10-11],從而有效緩解腸易激綜合癥(IBS)和炎癥性腸病(IBD)等胃腸道疾病,調節腸道菌群失調,改善腹部不適,腹脹,排便困難等癥狀。
1. 在腸道健康方面
長雙歧桿菌還具有免疫調節作用,可通過免疫調節作用產生抗炎細胞因子IL-22抑制異常Th2免疫反應和有效誘導Treg細胞免疫,保護宿主免受過敏性疾病和自身免疫性疾病等異常免疫反應[12-13],從而可提高機體免疫力,預防疾病和增強抵抗力。
2. 在心理健康方面
腸道中的菌群可以通過腸-腦軸來影響機體的精神狀態,保持健康、均衡的腸道菌群比例有利于改善焦慮、抑郁[14]。有研究表明長雙歧桿菌可改善機體對壓力情況的適應性、提高應對負面情緒的能力。如Pinto-Sanchez等人連續兩周給44名IBS患者每日服用1010 CFU/mL長雙歧桿菌NCC3001,結果表明可有效降低IBS患者的抑郁評分[15]。另一研究表明,給20位健康受試者連續4周服用109 CFU/mL長雙歧桿菌 1714Tm,可調節測試者在壓力下的大腦活動,并通過調節大腦某些區域的神經振蕩來影響大腦功能從而減少應激反應[16]。
3. 在心理健康方面
人體血液中膽固醇含量會導致動脈硬化和高血壓的發生,雙歧桿菌等有益菌可以影響膽固醇的代謝,將其轉化為人體不吸收的類固醇,降低血液中膽固醇的濃度,因而對高血壓和動脈硬化有一定的防治作用。如Xiao和Andrade等[17-18]研究發現,長雙歧桿菌BL1、長雙歧桿菌BB536均具有顯著的降膽固醇效果。長雙歧桿菌對癌癥也有一定的抑制作用,有研究表明長雙歧桿菌可有效抑制小鼠黑色素瘤的生長,提高小鼠生存率[19]。此外,補充單一益生菌長雙歧桿菌還可以改善老年(18 個月大)雌性小鼠的骨折修復過程[20]。

Part 4 國內外保藏情況
長雙歧桿菌在多個國際微生物菌種保藏中心均有保藏,其中CICC保藏有模式菌株CICC 6186,與多家國際知名菌種保藏中心模式菌株等同編號,如:ATCC 15707、JCM 1217、BCRC 11847,來源于成人腸道,可用于分類研究“種”的參考模型。此外,CICC還保藏有不同來源及用途的長雙歧桿菌,可作為標準菌株應用于相關領域的檢測,如:
CICC 6069
等同編號ATCC 15697,可作為陽性對照菌株,適用于《GB 4789.34-2012雙歧桿菌的鑒定》,同時還可作為質控菌株,適用于《GB 4789.28 培養基和試劑的質量要求》中MRS 培養基和莫匹羅星鋰鹽(Li-Mupirocin)改良MRS培養基的質量檢測。
CICC 6068
可作為陽性對照菌株,適用于《GB 4789.34-2012雙歧桿菌的鑒定》。
長雙歧桿菌特征特性
1. 革蘭氏陽性菌,菌體呈棒狀(0.5-0.7×1.3-3.5μm),長短、粗細不均,直或彎曲,膨脹成啞鈴形的細胞可分叉,單個或成對排列,不產芽孢,不運動。
2. 在BBL培養基上菌落呈圓形、白色,凸起,表面光滑、濕潤、邊緣整齊。
3. 嚴格厭氧,生長溫度范圍20~45℃,最適生長溫度36~38℃。
4. 耐酸,pH值范圍為6.5~7.0,在pH值為4.5-5.0以下或pH值為8.0~8.5以上一般不生長。

參考文獻
1. Arboleya S, Stanton C, Ryan C A, et al. Bosom Buddies: The symbiotic relationship between infants and Bifidobacterium longum ssp. Longum and ssp. infantis. genetic and probiotic features[J]. Annual Review of Food Science and Technology,2016, 7:1?21.
2. 王玉蓮,田萬紅,譚強來,魏華,曾明.雙歧桿菌的分類學研究與新進展[J].微生物學通報,2015,42(01):185-191.
3. 沈永才,袁佩娜. 雙歧桿菌的遺傳學分類方法研究進展[J]. 中國微生態學雜志, 2000, 12(3):171-173.
4. Goodfellow M, Kampfer P, Busse H J, et al. Bergey?s Manual of Systematic Bacteriology[M]. New York: Springer Science Business Media, 2012: 33-2028.
5. Yanokura E, Oki K, Makino H, Modesto M, Pot B, Mattarelli P, Biavati B, Watanabe K. Subspeciation of Bifidobacterium longum by multilocus approaches and amplified fragment length polymorphism: Description of B. longum subsp. suillum subsp. nov., isolated from the faeces of piglets. Syst Appl Microbiol 2015; 38:305-314.
6. 食品安全標準與監測評估司. 可用于食品的菌種名單和可用于嬰幼兒食品的菌種名單[Z]. 國家衛生健康委, 2022.
7. Modesto M, Ngom-Bru C, Scarafile D, Bruttin A, Pruvost S, Sarker SA, Ahmed T, Sakwinska O, Mattarelli P, Duboux S. Bifidobacterium longum subsp. iuvenis subsp. nov., a novel subspecies isolated from the faeces of weaning infants. Int J Syst Evol Microbiol 2023; 73:6013.
8. Bentley-Hewitt K L, Narbad A, Majsak-Newman G, et al. Lactobacilli survival and adhesion to colonic epithelial cell lines is dependent on long chain fatty exposure[J]. European Journal of Lipid Science and Technology, 2017(11):1700062.
9. Walter J, Maldonado-Gómez M X, Martínez I. To engraft or not to engraft: an ecological framework for gut microbiome modulation with live microbes [J]. Current Opinion in Biotechnology, 2018, 49: 129-139.
10. Turroni F, Foroni E, O'Connell Motherway M, et al. Characterization of the serpin-encoding gene of Bifidobacterium breve 210B [J]. Applied and Environmental Microbiology, 2010, 76(10): 3206-3219.
11. Bevilacqua L, Ovidi M, Mattia E D, et al. Screening of Bifidobacterium strains isolated from human faeces for antagonistic activities against potentially bacterial pathogens[J]. Microbiological research, 2003, 158, 179-185.
12. oure R, Kheadr E, Lacroix C, et al. Production of antibacterial substances by bifidobacterial isolates from infant stool active against Listeria monocytogenes[J]. Journal of Applied Microbiology, 2003,95, 1058-1069.
13. Fang Z F, Pan T, Li L Z, et al. Bifidobacterium longum mediated tryptophan metabolism to improve atopic dermatitis via the gut-skin axis [J]. Gut Microbes, 2022, 14(1): 2044723.
14. 馬燕, 郭莉娜, 劉漪淪. 腸道菌群與抑郁癥發生的研究進展 [J]. 實用醫學雜志, 2018, 34(2):324?327.
15. Pinto-Sanchez M I, Hall G B, Ghajar K, Nardelli A, Bolino C, Lau J T, Martin F P, Cominetti O, Welsh C, Rieder A, Traynor J, Gregory C, De Palma G, Pigrau M, Ford A C, Macri J, Berger B, Bergonzelli G, Surette M G, Collins S M, Moayyedi P, Bercik P. Probiotic Bifidobacterium longum NCC3001 Reduces Depression Scores and Alters Brain Activity: A Pilot Study in Patients With Irritable Bowel Syndrome. Gastroenterology. 2017, 153(2):448-459.
16. Wang H, Braun C, Murphy E F, Enck P. Bifidobacterium longum 1714? Strain Modulates Brain Activity of Healthy Volunteers During Social Stress. Am J Gastroenterol. 2019,114(7):1152-1162.
17. Xiao J Z,Kondo S,Takahashi N,et al. Effects of milk products fermented by Bifidobacterium longum on blood lipids in rats and healthy adult male volunteers[J]. Journal of Dairy Science, 2003, 86(7):2452-2461.
18. Andrade S,Borges N. Effect of fermented milk containing Lactobacillus acidophilus and Bifidobacterium longum on plasma lipids of women with normal or moderately elevated cholesterol[J]. Journal of Dairy Research, 2009,76(4):469-474.
19. Bender M J, McPherson A C, et al. Dietary tryptophan metabolite released by intratumoral Lactobacillus reuteri facilitates immune checkpoint inhibitor treatment. Cell. 2023,186(9):1846-1862.
20. Roberts J L, Golloshi M, Harding D B, Conduah M, Liu G, Drissi H. Bifidobacterium longum supplementation improves age-related delays in fracture repair. Aging Cell. 2023,22(4):e13786.


